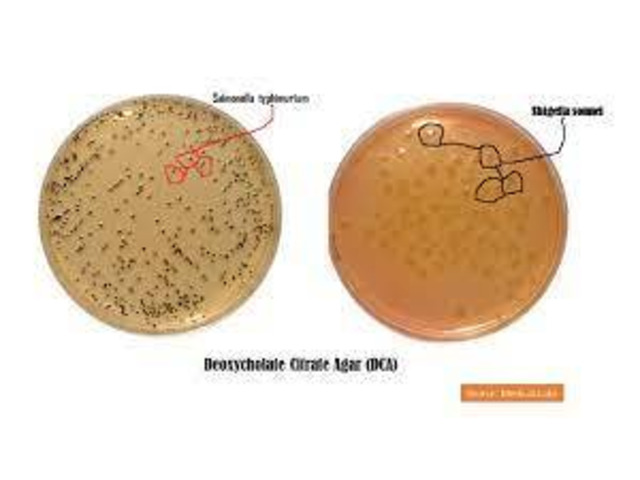

DCA Agar IN NIGERIA BY SCANTRIK MEDICAL SUPPLIES
DCA uses for the isolation and differentiation of enteric gram-negative bacilli from clinical (feces, blood) as well as food samples.
It is particularly useful for the isolation of organisms that cause bacillary dysentery (Shigella) , Salmonella strains that cause food poisoning, typhoid fever and Salmonella Paratyphi causes paratyphoid fever.
We are your One Stop Hub for Medical Equipment | Hospital Supplies | Lab Consumables | Surgical Instruments | Dental Care | Clinical Devices | PPE Kits | Disinfectants | Consumables & Disposables |Lab Diagnostics & Instruments | Medical Device & Equipment |Medical Implants | Hospital Establishment | Physiotherapy & Rehabilitation-Medical Aids | Mobility Aid | Medical Furniture | Gynaecology & Infant Care | Hospital Holloware | Lab Reagents | Radiology Equipment (Ultrasound, X-ray Machine, CT, MRI, ECG)
WE CAN SUPPLY AND INSTALL ANYWHERE IN NIGERIA
OFFICES IN LAGOS, ABUJA, PORT HARCOURT AND BENIN CITY
Please CALL: 0907-643-3020, 0904-936-7703
WhatsApp: https://wa.me/2349076433020
Email: info (AT) scantrikmedicalsupplies.com
Web: www.scantrikmedicalsupplies.com/products